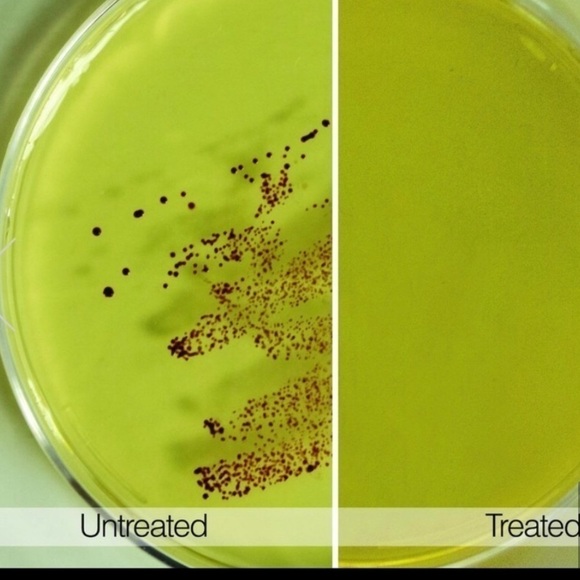
TECH Candy UV Sanitizer In Mint Green - Picture 5 of 15

TECH Candy UV Sanitizer In Mint Green
NWT
$55 $60
Pay in 4 interest-free payments of $13.75
with .
Learn More
.
Size
Like and save for later
Add To Bundle
Brand New… Hello Beauty! Welcome to my Closet and my wonderful corner, you can buy with confidence from my closet, as I am a "Posh Ambassador 2" I promise to package your items with love and care and sending you a free gift!!. Shipping same day or next business Day!
beautiful and lightweight. This device kills up to 99% of common germs in just 5 minutes, light/UVC technology and is used to kill bacteria, Viruses and other microorganisms, Includes: UV Sanitizer Device, Model TCN-TE-008-One USB Charging Cord 3.28ft, and Instructions, (Disinfects: Phones, Keys, Money, Smartphones, Headphones, ID Card, Jewelry, Watches, Remotes, Beauty Supplies, Makeup Brushes, Sponges, Baby Supplies, Pacifier, Toys, Sunglasses, Reading Glasses, Toothbrush, Comb, Travel Essentials, etc) Portable take it anywhere! Easy to use! Rechargeable..
Shipping/Discount
Trending Now
Find Similar Listings
Account is under Review
Comment posting is temporarily restricted. Our team will reach out to you shortly. To understand why, select
Learn More.